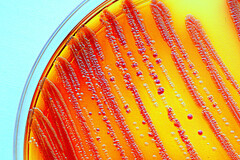

Thermalisme : le grand retour de l’eau qui soigne
Face à l’épidémie silencieuse des maladies chroniques, du stress généralisé et de l’épuisement psychique, une ancienne médecine refait surface : le thermalisme. De nombreuses stations thermales réinventent aujourd’hui leurs soins pour mieux répondre aux enjeux de santé de notre époque. Malgré un engouement qui ne se dément pas, le thermalisme n’a rien d’un phénomène de mode. Dax, Aix-les-Bains, Vichy, Bourbon-Lancy, Néris-les-Bains ou ...
rédigé le 15 avril 2025


 Découvrir le numéro
Découvrir le numéro